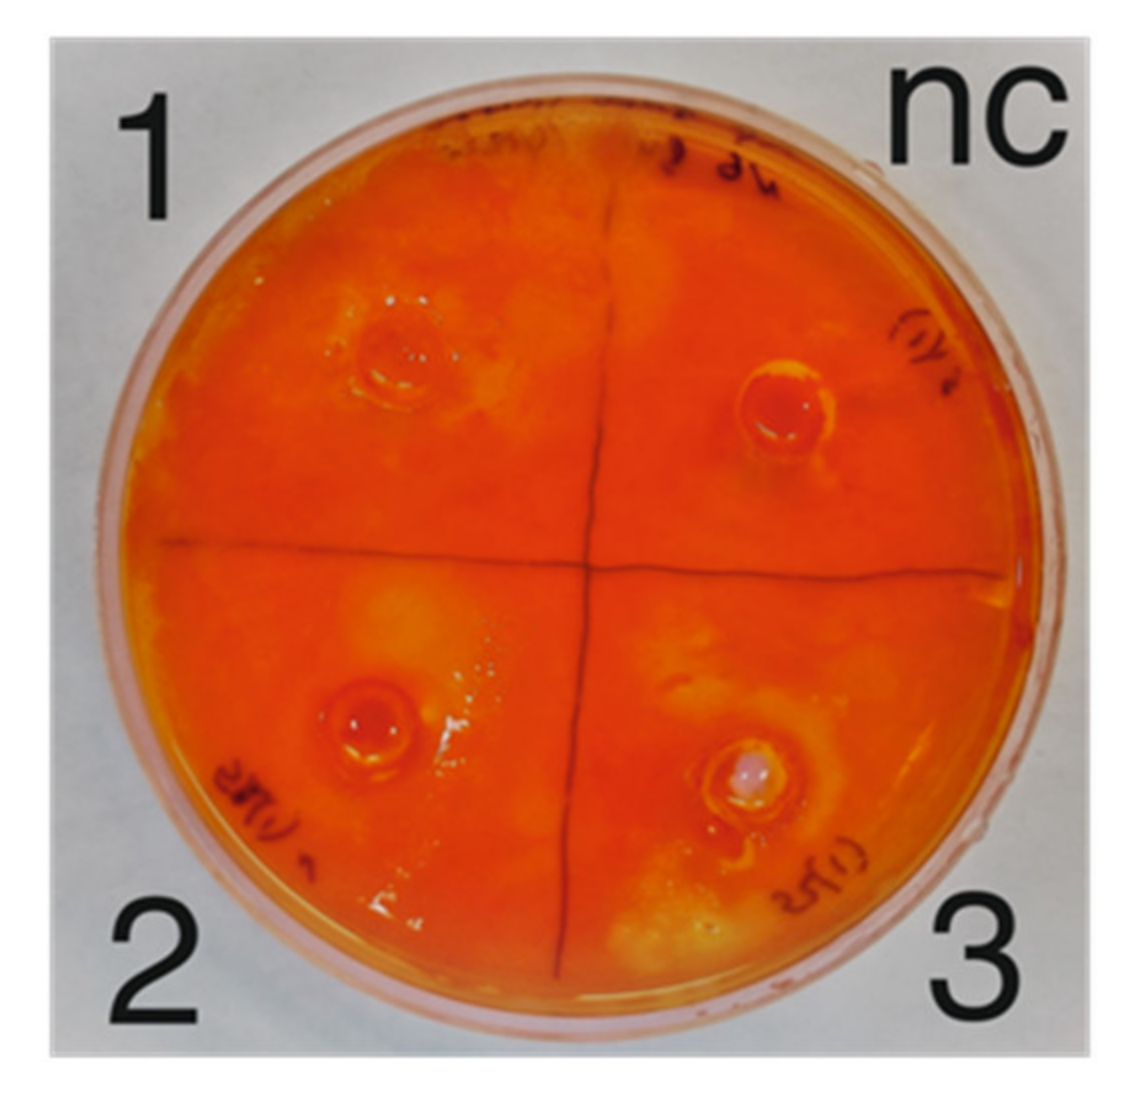
Microorganisms 09 01521 g004

First Insight into the Diversity and Antibacterial Potential of Psychrophilic and Psychotrophic Microbial Communities of Abandoned Amber Quarry
Abstract
:1. Introduction
2. Materials and Methods
2.1. Sample Collection
2.2. DNA Isolation and Purification
2.3. 16S rRNA Gene Amplicon Sequencing
2.4. Data Processing
2.5. Testing of Antibacterial and Cellulolytic Activity
3. Results
3.1. Microbial Diversity
3.2. Antibacterial and Cellulolytic Activity
4. Discussion
5. Conclusions
Author Contributions
Funding
Data Availability Statement
Conflicts of Interest
Appendix A

Appendix B

Appendix C

Appendix D

References
- Malik, B.; Bhattacharyya, S. Antibiotic drug-resistance as a complex system driven by socio-economic growth and antibiotic misuse. Sci. Rep. 2019, 9, 1–12. [Google Scholar]
- Lees, P.; Pelligand, L.; Giraud, E.; Toutain, P.L. A history of antimicrobial drugs in animals: Evolution and revolution. J. Vet. Pharmacol. Ther. 2021, 44, 137–171. [Google Scholar] [CrossRef]
- Blaser, M. Antibiotic overuse: Stop the killing of beneficial bacteria. Nature 2011, 476, 393–394. [Google Scholar] [CrossRef]
- Zhang, S.; Chen, D.C. Facing a new challenge: The adverse effects of antibiotics on gut microbiota and host immunity. Chin. Med. J. 2019, 132, 1135. [Google Scholar] [CrossRef]
- Iizumi, T.; Battaglia, T.; Ruiz, V.; Perez, G.I.P. Gut microbiome and antibiotics. Arch. Med Res. 2017, 48, 727–734. [Google Scholar] [CrossRef] [PubMed]
- Zimina, M.; Babich, O.; Prosekov, A.; Sukhikh, S.; Ivanova, S.; Shevchenko, M.; Noskova, S. Overview of Global Trends in Classification, Methods of Preparation and Application of Bacteriocins. Antibiotics 2020, 9, 553. [Google Scholar] [CrossRef] [PubMed]
- Kokoska, L.; Kloucek, P.; Leuner, O.; Novy, P. Plant-derived products as antibacterial and antifungal agents in human health care. Curr. Med. Chem. 2019, 26, 5501–5541. [Google Scholar] [CrossRef]
- Furfaro, L.L.; Payne, M.S.; Chang, B.J. Bacteriophage therapy: Clinical trials and regulatory hurdles. Front. Cell Infect. Microbiol 2018, 8, 376. [Google Scholar] [CrossRef] [Green Version]
- Coutinho, M.F.; Matos, L.; Santos, J.I.; Alves, S. RNA therapeutics: How far have we gone? Adv. Exp. Med. Biol. 2019, 1157, 133–177. [Google Scholar] [PubMed]
- Santacroce, L.; Charitos, I.A.; Bottalico, L. A successful history: Probiotics and their potential as antimicrobials. Expert Rev. Anti-Infect. Ther. 2019, 17, 635–645. [Google Scholar] [CrossRef]
- Kumar, P.; Kizhakkedathu, J.N.; Straus, S.K. Antimicrobial peptides: Diversity, mechanism of action and strategies to improve the activity and biocompatibility in vivo. Biomolecules 2018, 8, 4. [Google Scholar] [CrossRef] [PubMed] [Green Version]
- Prosekov, A.Y.; Dyshlyuk, L.S.; Milentyeva, I.S.; Sykhikh, S.A.; Babich, O.O.; Ivanova, S.A.; Pavsky, V.A.; Shishin, M.V.; Matskova, L.V. Antioxidant and antimicrobial activity of bacteriocin-producing strains of lactic acid bacteria isolated from the human gastrointestinal tract. Prog. Nutr. 2017, 19, 67–80. [Google Scholar]
- Barbour, A.; Wescombe, P.; Smith, L. Evolution of lantibiotic salivaricins: New weapons to fight infectious diseases. Trends Microbiol. 2020, 28, 578–593. [Google Scholar] [CrossRef] [PubMed]
- Boakes, S.; Ayala, T.; Herman, M.; Appleyard, A.N.; Dawson, M.J.; Cortés, J. Generation of an actagardine A variant library through saturation mutagenesis. Appl. Microbiol. Biotechnol. 2012, 95, 1509–1517. [Google Scholar] [CrossRef] [PubMed]
- Loiselle, M.; Anderson, K.W. The use of cellulase in inhibiting biofilm formation from organisms commonly found on medical implants. Biofouling 2003, 19, 77–85. [Google Scholar] [CrossRef] [PubMed]
- Kumar, A. Protein adaptations in extremophiles: An insight into extremophilic connection of mycobacterial proteome. Semin. Cell Dev. Biol. 2018, 2, 23–37. [Google Scholar] [CrossRef]
- Yadav, A.N.; Yadav, N.; Sachan, S.G.; Saxena, A.K. Biodiversity of psychrotrophic microbes and their biotechnological applications. J. Appl. Biol. Biotechnol. 2019, 7, 99–108. [Google Scholar]
- Chen, G.Q.; Jiang, X.R. Next generation industrial biotechnology based on extremophilic bacteria. Curr. Opin. Biotechnol. 2018, 50, 94–100. [Google Scholar] [CrossRef]
- Fadrosh, D.W.; Ma, B.; Gajer, P.; Sengamalay, N.; Ott, S.; Brotman, R.M.; Ravel, J. An improved dual-indexing approach for multiplexed 16S rRNA gene sequencing on the Illumina MiSeq platform. Microbiome 2014, 2, 1–7. [Google Scholar] [CrossRef] [PubMed] [Green Version]
- Kuczynski, J.; Stombaugh, J.; Walters, W.A.; González, A.; Caporaso, J.G.; Knight, R. Using QIIME to analyze 16S rRNA gene sequences from microbial communities. Curr. Protoc. Microbiol. 2012, 27, 1E-5. [Google Scholar] [CrossRef] [PubMed] [Green Version]
- Bokulich, N.A.; Kaehler, B.D.; Rideout, J.R.; Dillon, M.; Bolyen, E.; Knight, R.; Huttley, G.A.; Caporaso, J.G. Optimizing taxonomic classification of marker-gene amplicon sequences with QIIME 2’s q2-feature-classifier plugin. Microbiome 2018, 6, 1–17. [Google Scholar] [CrossRef]
- Wu, C.H.; Apweiler, R.; Bairoch, A.; Natale, D.A.; Barker, W.C.; Boeckmann, B.; Ferro, S.; Gasteiger, E.; Huang, H.; Lopez, R.; et al. The Universal Protein Resource (UniProt): An expanding universe of protein information. Nucleic Acids Res. 2006, 34 (Suppl. S1), D187–D191. [Google Scholar] [CrossRef] [PubMed]
- Calle, M.L. Statistical analysis of metagenomics data. Genom. Inform. 2019, 17. [Google Scholar] [CrossRef]
- Wagner, B.D.; Grunwald, G.K.; Zerbe, G.O.; Mikulich-Gilbertson, S.K.; Robertson, C.E.; Zemanick, E.T.; Harris, J.K. On the use of diversity measures in longitudinal sequencing studies of microbial communities. Front. Microbiol. 2018, 9, 1037. [Google Scholar] [CrossRef] [Green Version]
- Gupta, P.; Samant, K.; Sahu, A. Isolation of Cellulose-Degrading Bacteria and Determination of Their Cellulolytic Potential. Int. J. Med. 2012, 2012, 1–5. [Google Scholar] [CrossRef] [Green Version]
- López-Mondéjar, R.; Zühlke, D.; Becher, D.; Riedel, K.; Baldrian, P. Cellulose and hemicellulose decomposition by forest soil bacteria proceeds by the action of structurally variable enzymatic systems. Sci. Rep. 2016, 6, 1–12. [Google Scholar]
- Kim, E.S.; Kim, B.S.; Kim, K.Y.; Woo, H.M.; Lee, S.M.; Um, Y. Aerobic and anaerobic cellulose utilization by Paenibacillus sp. CAA11 and enhancement of its cellulolytic ability by expressing a heterologous endoglucanase. J. Biotechnol. 2018, 268, 21–27. [Google Scholar] [CrossRef] [PubMed]
- Rodrigues, D.F.; Tiedje, J.M. Coping with our cold planet. Appl. Environ. Microbiol. 2008, 74, 1677–1686. [Google Scholar] [CrossRef] [Green Version]
- Lauro, F.M.; Bartlett, D.H. Prokaryotic lifestyles in deep sea habitats. Extremophiles 2008, 12, 15–25. [Google Scholar] [CrossRef] [PubMed]
- Parvizpour, S.; Hussin, N.; Shamsir, M.S.; Razmara, J. Psychrophilic enzymes: Structural adaptation, pharmaceutical and industrial applications. Appl. Microbiol. Biotechnol. 2021, 105, 899–907. [Google Scholar] [CrossRef]
- Hamdan, A. Psychrophiles: Ecological significance and potential industrial application. S. Afr. J. Sci. 2018, 114, 1–6. [Google Scholar] [CrossRef]
- Tomova, I.; Stoilova-Disheva, M.; Lazarkevich, I.; Vasileva-Tonkova, E. Antimicrobial activity and resistance to heavy metals and antibiotics of heterotrophic bacteria isolated from sediment and soil samples collected from two Antarctic islands. Front. Life Sci. 2015, 8, 348–357. [Google Scholar] [CrossRef]
- Lee, J.; Cho, Y.J.; Yang, J.Y.; Jung, Y.J.; Hong, S.G.; Kim, O.S. Complete genome sequence of Pseudomonas antarctica PAMC 27494, a bacteriocin-producing psychrophile isolated from Antarctica. J. Biotechnol. 2017, 259, 15–18. [Google Scholar] [CrossRef]
- Rajasekharan, S.K.; Ramesh, S. Cellulase inhibits Burkholderia cepacia biofilms on diverse prosthetic materials. Pol. J. Microbiol. 2013, 62, 327–330. [Google Scholar] [CrossRef]
- Gupta, S.K.; Kataki, S.; Chatterjee, S.; Prasad, R.K.; Datta, S.; Vairale, M.G.; Sharma, S.; Dwivedi, S.K.; Gupta, D.K. Cold adaptation in bacteria with special focus on cellulase production and its potential application. J. Clean. Prod. 2020, 258, 120351. [Google Scholar] [CrossRef]
- Biddle, A.; Stewart, L.; Blanchard, J.; Leschine, S. Untangling the genetic basis of fibrolytic specialization by Lachnospiraceae and Ruminococcaceae in diverse gut communities. Diversity 2013, 5, 627–640. [Google Scholar] [CrossRef]
- Hahnke, S.; Abendroth, C.; Langer, T.; Codoñer, F.M.; Ramm, P.; Porcar, M.; Porcar, M.; Luschnig, O.; Klocke, M. Complete genome sequence of a new Ruminococcaceae bacterium isolated from anaerobic biomass hydrolysis. Genome Announc. 2018, 6, e00030-18. [Google Scholar] [CrossRef] [PubMed] [Green Version]
- Huang, X.; Liu, L.; Zhao, J.; Zhang, J.; Cai, Z. The families Ruminococcaceae, Lachnospiraceae, and Clostridiaceae are the dominant bacterial groups during reductive soil disinfestation with incorporated plant residues. Appl. Soil Ecol. 2019, 135, 65–72. [Google Scholar] [CrossRef]
- Baldwin, S.A.; Mattes, A.; Rezadehbashi, M.; Taylor, J. Seasonal microbial population shifts in a bioremediation system treating metal and sulfate-rich seepage. Minerals 2016, 6, 36. [Google Scholar] [CrossRef] [Green Version]
- Montero-Calasanz, M.D.C.; Meier-Kolthoff, J.P.; Zhang, D.F.; Yaramis, A.; Rohde, M.; Woyke, T.; Kyrpides, N.C.; Schumann, P.; Li, W.J.; Göker, M. Genome-scale data call for a taxonomic rearrangement of Geodermatophilaceae. Front. Microbiol. 2017, 8, 2501. [Google Scholar] [CrossRef] [Green Version]
- Lajis, A.F.B. Biomanufacturing process for the production of bacteriocins from Bacillaceae family. Bioresour. Bioprocess. 2020, 7, 1–26. [Google Scholar] [CrossRef]
- Maan, P.K.; Garcha, S. Bacteriocins from Gram-negative Rhizobium spp. Adv. Biores. 2018, 9. [Google Scholar] [CrossRef]
- Wiegand, S.; Jogler, M.; Boedeker, C.; Pinto, D.; Vollmers, J.; Rivas-Marín, E.; Kohn, T.; Peeters, S.H.; Heuer, A.; Rast, P.; et al. Cultivation and functional characterization of 79 planctomycetes uncovers their unique biology. Nat. Microbiol. 2020, 5, 126–140. [Google Scholar] [CrossRef] [PubMed]
- Wilhelm, R.C.; Cardenas, E.; Leung, H.; Szeitz, A.; Jensen, L.D.; Mohn, W.W. Long-term enrichment of stress-tolerant cellulolytic soil populations following timber harvesting evidenced by multi-omic stable isotope probing. Front. Microbiol. 2017, 8, 537. [Google Scholar] [CrossRef] [PubMed] [Green Version]

| Component | Content, g/L |
|---|---|
| MgSO4 × 7H2O | 0.2 |
| CaCl2 × 2H2O | 0.02 |
| KH2PO4 | 1.0 |
| K2HPO4 | 1.0 |
| (NH4)2SO4 | 0.5 |
| FeCl3 | 0.02 |
| Peptone/casamino acids | 10.0 |
| Yeast extract | 5.0 |
| Components | Mediums | ||||
|---|---|---|---|---|---|
| 1 | 2 | 3 | 4 | 5 | |
| NaCl, g/L | 20 | 15 | 10 | - | - |
| KCl, g/L | 2.0 | 2.0 | 2.0 | 0.5 | 0.5 |
| NH4Cl, g/L | 0.25 | 0.25 | 0.25 | - | - |
| K2HPO4, g/L | 2.5 | 2.5 | 2.5 | 1.8 | 1.8 |
| MgSO4, g/L | - | - | - | 0.9 | 0.9 |
| NaNO3, g/L | - | - | - | 1 | 1 |
| Carbomethylcellulose, g/L | - | - | - | 5 | 2 |
| Amorphous cellulose, g/L | 5 | 5 | 5 | - | - |
| Sample | Lysis Zone Diameter, mm | |
|---|---|---|
| E. coli | B. subtilis | |
| S10 | 16 | 18 |
| S15 | 13 | 17 |
| S17 | 14 | 17 |
| S20 | 15 | 13 |
| Ampicillin | 13 | 21 |
| Negative control | - | - |
Publisher’s Note: MDPI stays neutral with regard to jurisdictional claims in published maps and institutional affiliations. |
© 2021 by the authors. Licensee MDPI, Basel, Switzerland. This article is an open access article distributed under the terms and conditions of the Creative Commons Attribution (CC BY) license (https://creativecommons.org/licenses/by/4.0/).
Share and Cite
Shevchenko, M.; Sukhikh, S.; Babich, O.; Noskova, S.; Ivanova, S.; Lisun, V.; Skripskaya, V.; Lomtev, A.; Zimina, M. First Insight into the Diversity and Antibacterial Potential of Psychrophilic and Psychotrophic Microbial Communities of Abandoned Amber Quarry. Microorganisms 2021, 9, 1521. https://doi.org/10.3390/microorganisms9071521
Shevchenko M, Sukhikh S, Babich O, Noskova S, Ivanova S, Lisun V, Skripskaya V, Lomtev A, Zimina M. First Insight into the Diversity and Antibacterial Potential of Psychrophilic and Psychotrophic Microbial Communities of Abandoned Amber Quarry. Microorganisms. 2021; 9(7):1521. https://doi.org/10.3390/microorganisms9071521
Chicago/Turabian StyleShevchenko, Margarita, Stanislav Sukhikh, Olga Babich, Svetlana Noskova, Svetlana Ivanova, Valery Lisun, Viktoriya Skripskaya, Andrey Lomtev, and Maria Zimina. 2021. "First Insight into the Diversity and Antibacterial Potential of Psychrophilic and Psychotrophic Microbial Communities of Abandoned Amber Quarry" Microorganisms 9, no. 7: 1521. https://doi.org/10.3390/microorganisms9071521
APA StyleShevchenko, M., Sukhikh, S., Babich, O., Noskova, S., Ivanova, S., Lisun, V., Skripskaya, V., Lomtev, A., & Zimina, M. (2021). First Insight into the Diversity and Antibacterial Potential of Psychrophilic and Psychotrophic Microbial Communities of Abandoned Amber Quarry. Microorganisms, 9(7), 1521. https://doi.org/10.3390/microorganisms9071521

